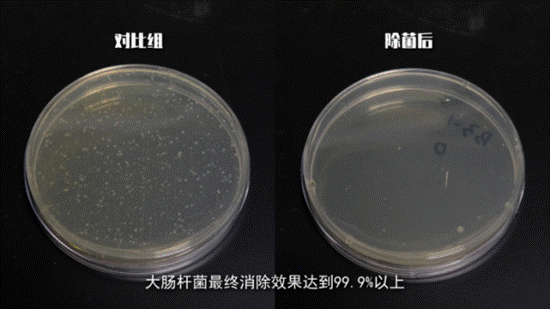

原标题:除螨仪效果实测 家电院发布莱克除螨仪测试实验视频
螨虫是一种微小的寄生生物,长期存在于人们的生活环境当中。它们以人体或动物脱落的皮屑和角质细胞为食,往往在床垫,被子,枕头,沙发,地毯等处大量滋生。螨虫虫体、虫卵、唾液、排泄物等作为强力的过敏原,极易引发皮炎、哮喘、支气管炎、肾炎等病症。
“三月不晒被,百万螨虫陪你睡”。为了解决掉这些朝夕相处的潜在威胁,市面上出现了不少应对螨虫的办法以及工具,比如除螨仪。除螨仪真的有效吗?到底什么样的除螨仪才能真正除螨呢?
近日,UET用户体验测评实验室(由中国家用电器研究院发起的,中国唯一个由行业领导机构建立的基于用户体验的产品评价体系)发布了中国家电院测评莱克除螨仪的实验视频,对市场上销售排名第一的莱克除螨仪B302pro进行了检测,并对除螨仪的各项性能做出了评价。

试验结果显示
除螨仪并非智商税,强拍打是深层除螨的关键
试验发现,除螨仪真的可以高效除螨。同时,拍打功能所实现的深层次除螨对于除螨效果起到至关重要的作用。家电院的工作人员分别选择了同等吸力下带拍打滚刷的除螨仪和不带拍打滚刷的除螨仪,对5000±500只活体螨虫进行了除螨操作。

试验结果显示,具备拍打功能的除螨仪除螨率可达90%以上,而不带拍打功能的除螨仪除螨率仅为63.1%,具备拍打模块的除螨仪除螨效果整体上要优于单纯吸入式的除螨仪。试验还发现,尽管大吸力是决定除螨仪除螨效果的重要因素,但事实上,拍打功能是决定能否清理深层次螨虫的关键一环,足够强度的拍打是保证深层除螨效果的根本。

为了实际对比测评莱克除螨仪的拍打效果,家电院选取了莱克除螨仪和市面上的普通除螨仪,设计进行了米粒震动实验。

从实验画面可以看出,莱克除螨仪每分钟拍打50000次的国家专利强拍打滚刷,拍打深度可至25cm,而普通除螨仪的拍打效果微乎其微。在进行除螨工作时,普通除螨仪的弱拍打仅能做一个表面的清洁,而莱克除螨仪的强拍打功能,能够有效拔除清理床铺深层螨虫以及螨虫尸体,排泄物等强过敏原,真正祛除螨虫。
测试吸力的凹槽小球实验中,莱克除螨仪14000pa的超大吸力,隔着薄被可以将距离薄被20cm的小球轻松吸起,大吸力完全足以胜任日常除螨。

超声波可有效除螨抑螨
莱克除螨仪B302 pro内置有超声波发射器。
家电院对莱克吉米除螨仪的超声波抑螨功能测试显示,莱克除螨仪所发射的特殊频段的超声波作用于螨虫的中枢神经系统,可以使螨虫停止进食,繁殖并逐渐死亡,能够有效的抑制螨虫活性。同时实验测评还指出:莱克除螨仪内置的超声波发射器是功率2W都不到的微电子产品,它所发射的特殊频段的超声波对人体和宠物无害,仅作用于螨虫。属于物理除螨,母婴可用。

紫外线功能有效杀菌
家电院试验报告还介绍,紫外线杀菌功能是除螨仪杀菌的关键。工作人员培养采集了标准数量的大肠杆菌对莱克吉米除螨仪UV紫外线功能进行实机检测。测试结果显示,莱克B302 pro除螨仪所采用的医用级紫外线,除菌率高达99.9%,高效迅速,杀菌效果值得肯定。
消费提示
UET用户体验测评实验室提醒大家,选购除螨仪应注意以下要点
1.选购除螨仪时,大吸力并非衡量除螨仪除螨效果的唯一标准,同时具备拍打功能的除螨仪除螨率要远高于单纯吸入式除螨仪的除螨率,且拍打强度越大,深层除螨越彻底。
2.超声波抑螨和紫外线杀菌可有效帮助提升除螨效率
3.定期除螨,增加使用频次才能得到好的除螨效果。可以增加机器使用的频次,而且每次使用增加往复吸除的次数。


